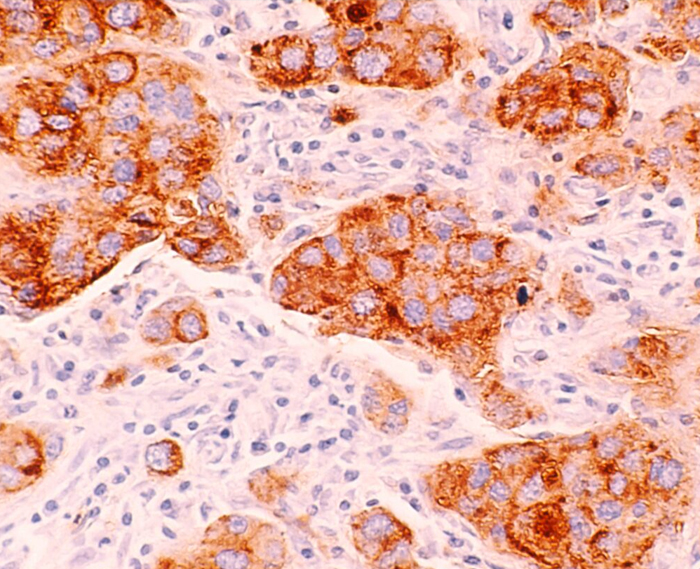

Aree Specialistiche
Dermatologia
Il nostro reparto di Dermatologia studia e cura le patologie cutanee, ovvero le malattie che colpiscono la pelle, i capelli, le unghie e le mucose, e i loro annessi.
Le cause possono essere diverse, come fattori ereditari, infezioni (batteriche, virali, fungine), agenti esterni, infiammazioni o problemi autoimmuni.
La visita dermatologica è essenziale per la diagnosi e il trattamento di un’ampia varietà di condizioni, tra cui acne, psoriasi, dermatiti, eczemi, funghi, infezioni batteriche, verruche e tumori cutanei come il melanoma.

Esistono moltissime patologie cutanee, che si possono classificare per causa o tipologia:
• Infiammazioni: Psoriasi, dermatite atopica, dermatite da contatto, eczema, acne, orticaria.
• Infezioni: Verruche (virali), funghi (micosi), impetigine (batterica), scabbia (parassitaria).
• Tumori cutanei: Melanoma, carcinoma basocellulare, nevi.
• Disturbi dei capelli: Alopecia, follicolite, forfora.
• Disturbi delle unghie: Micosi ungueali, onicopatie.
• Disturbi della pigmentazione: Vitiligine, lentiggini, iperpigmentazione.
• Malattie autoimmuni: Lupus cutaneo, pemfigoide, vitiligine.
I sintomi includono prurito, dolore, bruciore o sensazione di secchezza. I segni possono essere variazioni di colore, come macchie, arrossamenti o lesioni, ma anche ulcere, cisti, verruche o desquamazione.